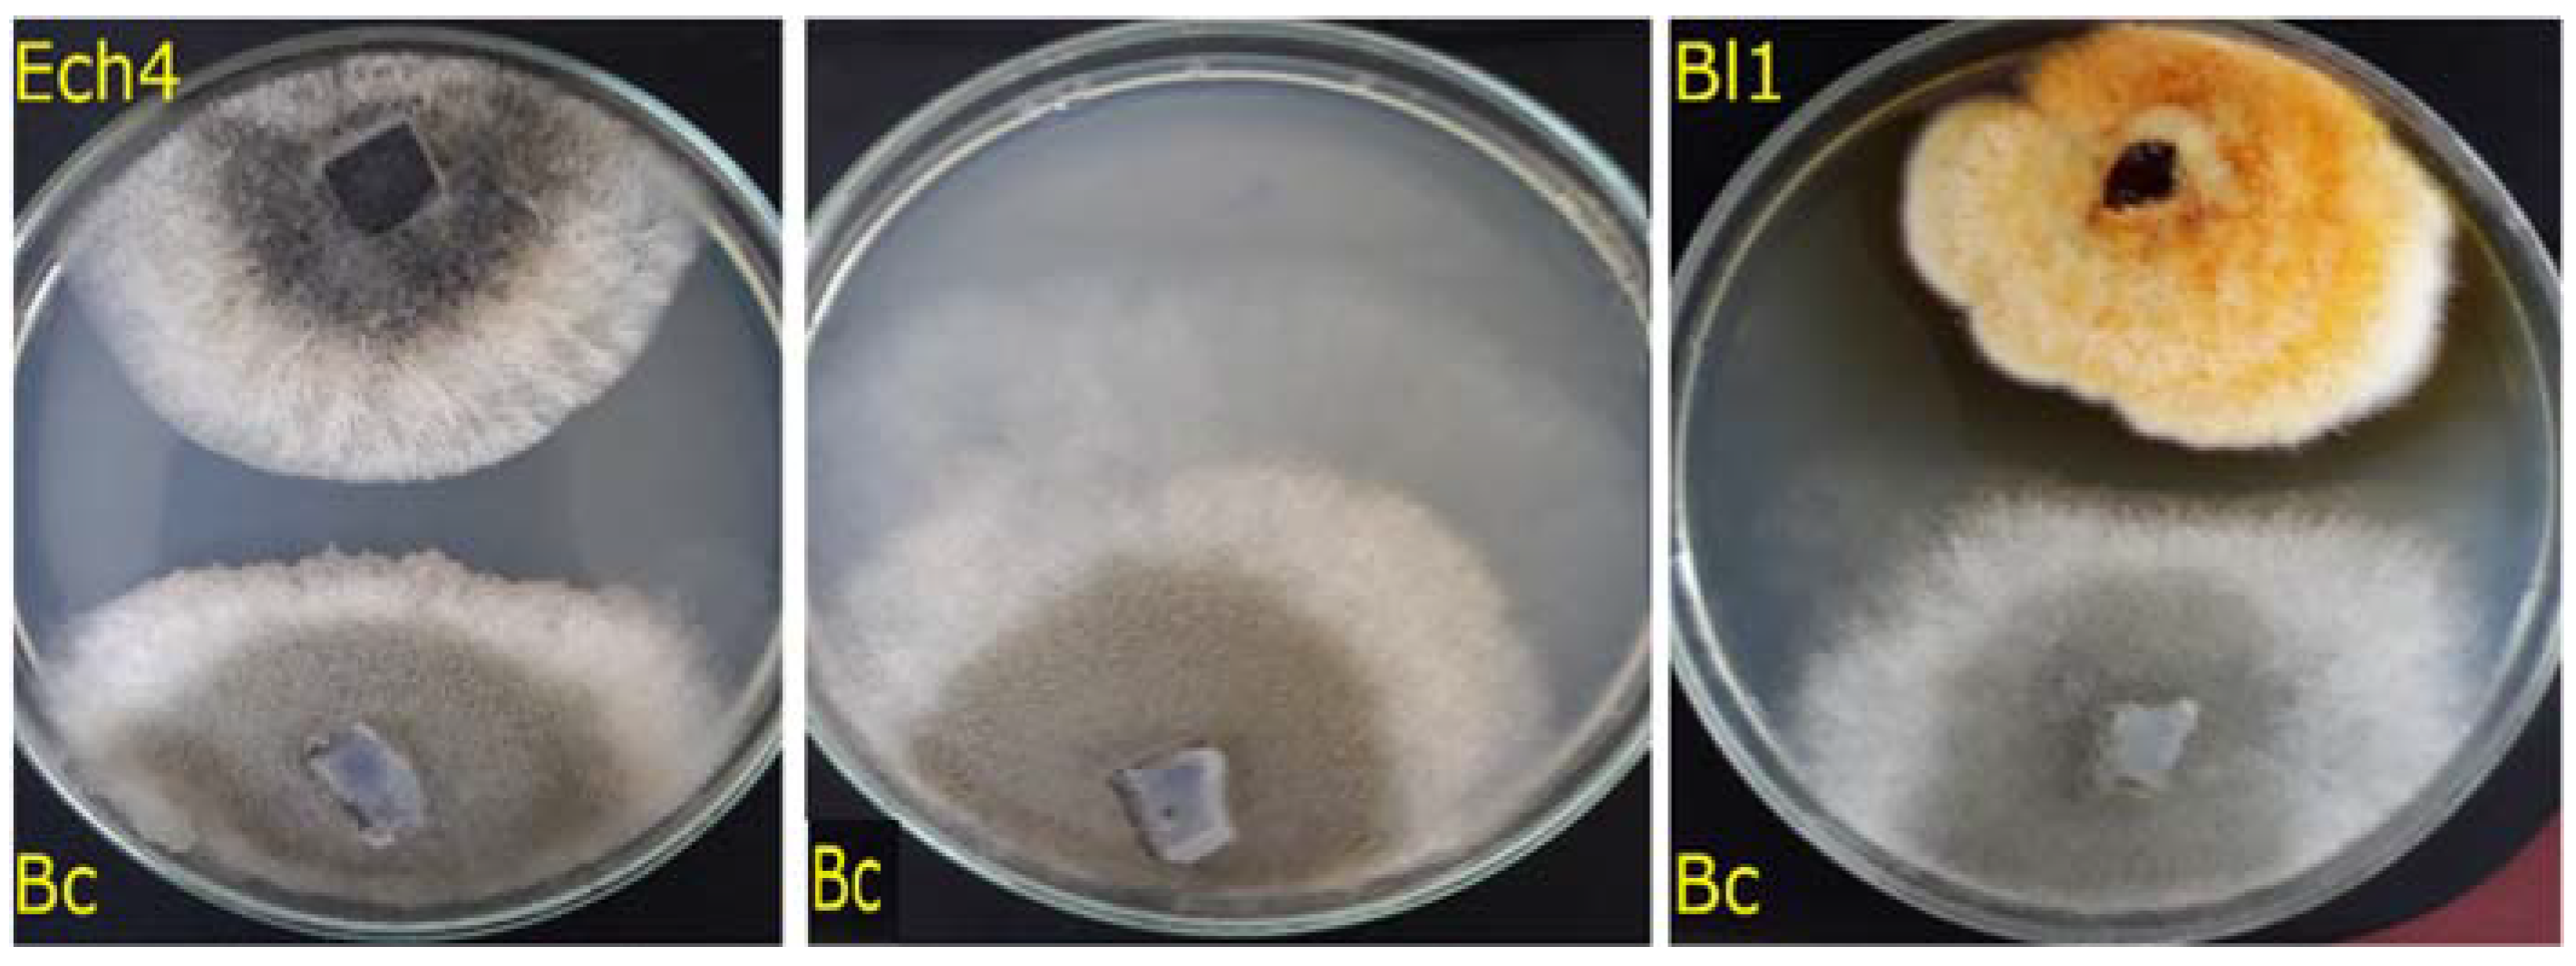
Jof 08 00197 g003

Endophytic Fungi Isolated from Baccharis linearis and Echinopsis chiloensis with Antifungal Activity against Botrytis cinerea
Abstract
1. Introduction
2. Materials and Methods
2.1. Collection of Plant Materials
2.2. Isolation of Endophytes
2.3. Antifungal Assays against B. cinerea
Confrontation Assays
2.4. Identification of Endophytes
2.5. Extraction of Secondary Metabolites from the Most Active Endophytic Fungi
2.6. Antifungal Activity against B. Cinerea of the Extracts
2.7. Statistical Analysis
3. Results
3.1. Isolation of Endophytes
3.2. Antifungal Activity against B. cinerea of the Extracts
3.3. Identification of Endophytes with Antifungal Activity
4. Discussion
Author Contributions
Funding
Institutional Review Board Statement
Informed Consent Statement
Data Availability Statement
Acknowledgments
Conflicts of Interest
References
- Fillinger, S.; Elad, Y. Botrytis-the Fungus, the Pathogen and Its Management in Agricultural Systems, 1st ed.; Springer: Cham, Switzerland, 2016; pp. 189–216. [Google Scholar]
- Baćmaga, M.; Wyszkowska, J.; Kucharski, J. The biochemical activity of soil contaminated with fungicides. J. Environ. Sci. Health Part B Pestic. Food Contam. Agric. Wastes 2019, 54, 252–262. [Google Scholar] [CrossRef]
- Hahn, M. The rising threat of fungicide resistance in plant pathogenic fungi: Botrytis as a case study. J. Chem. Biol. 2014, 7, 133–141. [Google Scholar] [CrossRef] [PubMed]
- Esterio, M.; Copier, C.; Román, A.; Araneda, M.J.; Rubilar, M.; Pérez, I.; Auger, J. Frequency of fungicide-resistant Botrytis cinerea populations isolated from ‘Thompson Seedless’ table grapes in the Central Valley of Chile. Sci. Investig. Agrar. 2017, 44, 295–306. [Google Scholar] [CrossRef][Green Version]
- Roca-Couso, R.; Flores-Féli, J.D.; Rivas, R. Mechanisms of action of microbial biocontrol agents against Botrytis cinerea. J. Fungi 2021, 7, 1045. [Google Scholar] [CrossRef]
- Gholami-Shabani, M.; Shams-Ghahfarokhi, M.; Razzaghi-Abyaneh, M. Natural product synthesis by fungi: Recent trends and future prospects. In Recent Advancement in White Biotechnology Through Fungi; Springer: Cham, Switzerland, 2019; pp. 385–401. [Google Scholar]
- Selim, K.A.; El-Beih, A.A.; AbdEl-Rahman, T.M.; El-Diwany, A.I. Biology of endophytic fungi. Curr. Res. Environ. Appl. Mycol. 2012, 2, 31–82. [Google Scholar] [CrossRef]
- Jia, M.; Chen, L.; Xin, H.L.; Zheng, C.J.; Rahman, K.; Han, T.; Qin, L.P. A friendly relationship between endophytic fungi and medicinal plants: A systematic review. Front. Microbiol. 2016, 7, 1–14. [Google Scholar] [CrossRef]
- Schulz, B.; Boyle, C.; Draeger, S.; Römmert, A.K.; Krohn, K. Endophytic fungi: A source of novel biologically active secondary metabolites. Mycol. Res. 2002, 106, 996–1004. [Google Scholar] [CrossRef]
- Deshmukh, S.K.; Gupta, M.K.; Prakash, V.; Saxena, S. Endophytic fungi: A source of potential antifungal compounds. J. Fungi 2018, 4, 77. [Google Scholar] [CrossRef]
- Vidal, A.; Parada, R.; Mendoza, L.; Cotoras, M. Endophytic fungi isolated from plants growing in central andean precordillera of chile with antifungal activity against Botrytis cinerea. J. Fungi 2020, 6, 149. [Google Scholar] [CrossRef]
- Xu, D.; Zhang, B.-Y.; Yang, X.-L. Antifungal monoterpene derivatives from the plant endophytic fungus Pestalotiopsis foedan. Chem. Biodivers. 2016, 13, 1422–1425. [Google Scholar] [CrossRef]
- Sun, P.; Huo, J.; Kurtán, T.; Mándi, A.; Antus, S.; Tang, H.; Draeger, S.; Schulz, B.; Hussain, H.; Krohn, K.; et al. Structural and stereochemical studies of hydroxyanthraquinone derivatives from the endophytic fungus Coniothyrium sp. Chirality 2013, 25, 141–148. [Google Scholar] [CrossRef] [PubMed]
- Richardson, S.N.; Walker, A.K.; Nsiama, T.K.; McFarlane, J.; Sumarah, M.; Ibrahim, A.; Miller, J.D. Griseofulvin-producing Xylaria endophytes of Pinus strobus and Vaccinium angustifolium: Evidence for a conifer-understory species endophyte ecology. Fungal Ecol. 2014, 11, 107–113. [Google Scholar] [CrossRef]
- Wang, J.; Wang, G.; Zhang, Y.; Zheng, B.; Zhang, C.; Wang, L. Isolation and identification of an endophytic fungus Pezicula sp. in Forsythia viridissima and its secondary metabolites. World J. Microbiol. Biotechnol. 2014, 30, 2639–2644. [Google Scholar] [CrossRef] [PubMed]
- Bai, Y.-B.; Gao, Y.-Q.; Nie, X.-D.; Tuong, T.-M.; Li, D.; Gao, J.-M. Antifungal activity of griseofulvin derivatives against phytopathogenic fungi in vitro and in vivo and three-dimensional quantitative structure-activity relationship analysis. J. Agric. Food Chem. 2019, 67, 6125–6132. [Google Scholar] [CrossRef] [PubMed]
- Hormazábal, E.; Piontelli, E. Endophytic fungi from Chilean native gymnosperms: Antimicrobial activity against human and phytopathogenic fungi. World J. Microbiol. Biotechnol. 2009, 25, 813–819. [Google Scholar] [CrossRef]
- González-Teuber, M. The defensive role of foliar endophytic fungi for a South American tree. AoB Plants 2016, 8, plw050. [Google Scholar] [CrossRef]
- Strobel, G.; Daisy, B. Bioprospecting for microbial endophytes and their natural products. Microbiol. Mol. Biol. Rev. 2003, 67, 491–502. [Google Scholar] [CrossRef]
- Ovalle, C.; Del Pozo, A.; Casado, M.A.; Acosta, B.; De Miguel, J.M. Consequences of landscape heterogeneity on grassland diversity and productivity in the Espinal agroforestry system of central Chile. Landsc. Ecol. 2006, 21, 585–594. [Google Scholar] [CrossRef]
- Rundel, P.W.; Arroyo, M.T.; Cowling, R.M.; Keeley, J.E.; Lamont, B.B.; Vargas, P. Mediterranean biomes: Evolution of their vegetation, floras, and climate. Annu. Rev. Ecol. Evol. Syst. 2016, 47, 383–407. [Google Scholar] [CrossRef]
- Oses-Pedraza, R.; Hernández, V.; Campos, L.; Becerra, J.; Irribarren-Riquelme, D.; Lavín, P.; Rodríguez, J. Advances in research on biodiversity and bioprospecting of endophytic fungi in Chile. In Neotropical Endophytic Fungi, 1st ed.; Rosa, L.H., Ed.; Springer: Cham, Switzerland, 2021; Volume 1, pp. 53–91. [Google Scholar]
- Walter, H.E. Floral biology of Echinopsis chiloensis ssp. chiloensis (Cactaceae): Evidence for a mixed pollination syndrome. Flora Morphol. Distrib. Funct. Ecol. Plants 2010, 205, 757–763. [Google Scholar] [CrossRef]
- Aljaro, M.E.; Frias, D.; Montenegro, G. Life cycle of Rhachiptera limbata (Diptera, Tephritidae) and its relationship with Baccharis linearis (Compositae). Rev. Chil. Hist. Nat. 1984, 57, 123–129. [Google Scholar]
- Gazitúa, M.C.; Morgante, V.; Poupin, M.J.; Ledger, T.; Rodríguez-Valdecantos, G.; Herrera, C.; González-Chávez, M.D.C.; Ginocchio, R.; González, B. The microbial community from the early-plant colonizer (Baccharis linearis) is required for plant establishment on copper mine tailings. Sci. Rep. 2021, 11, 10448. [Google Scholar] [CrossRef] [PubMed]
- Silva-Hughes, A.F.; Wedge, D.E.; Cantrell, C.L.; Carvalho, C.R.; Pan, Z.; Moraes, R.M.; Madoxx, V.L.; Rosa, L.H. Diversity and antifungal activity of the endophytic fungi associated with the native medicinal cactus Opuntia humifusa (Cactaceae) from the United States. Microbiol. Res. 2015, 175, 67–77. [Google Scholar] [CrossRef] [PubMed]
- Muñoz, G.; Hinrichsen, P.; Brygoo, Y.; Giraud, T. Genetic characterisation of Botrytis cinerea populations in Chile. Mycol. Res. 2002, 106, 594–601. [Google Scholar] [CrossRef]
- Chen, P.-H.; Chen, R.-Y.; Chou, J.-Y. Screening and evaluation of yeast antagonists for biological control of Botrytis cinerea on strawberry fruits. Mycobiology 2018, 46, 33–46. [Google Scholar] [CrossRef] [PubMed]
- Irfan, M.; Ting, Z.T.; Yang, W.; Chunyu, Z.; Qing, M.; Lijun, Z.; Feng, L. Modification of CTAB protocol for maize genomic DNA extraction. Res. J. Biotechnol. 2013, 8, 41–45. [Google Scholar]
- Raja, H.A.; Miller, A.N.; Pearce, C.J.; Oberlies, N.H. Fungal identification using molecular tools: A primer for the natural products research community. J. Nat. Prod. 2017, 80, 756–770. [Google Scholar] [CrossRef]
- White, T.J.; Bruns, T.; Lee, S.; Taylor, J.W. Amplification and direct sequencing of fungal ribosomal RNA genes for phylogenetics. PCR Protoc. 1990, 18, 315–322. [Google Scholar] [CrossRef]
- Hubka, V.; Kolarik, M. β-tubulin paralogue tubC is frequently misidentified as the benA gene in Aspergillus section Nigri taxonomy: Primer specificity testing and taxonomic consequences. Persoonia 2012, 29, 1–10. [Google Scholar] [CrossRef]
- Choma, I.M.; Grzelak, E.M. Bioautography detection in thin-layer chromatography. J. Chromatogr. A 2011, 1218, 2684–2691. [Google Scholar] [CrossRef]
- Dissanayak, M.; Ito, S.-I.; Akakabe, Y. TLC bioautography guided detection and biological activity of antifungal compounds from medicinal plant Acorus calamus Linn. Asian J. Plant Pathol. 2015, 9, 16–26. [Google Scholar] [CrossRef][Green Version]
- Visweswari, G.; Christopher, R.; Rajendra, W. Phytochemical screening of active secondary metabolites present in Withania somnifera root: Role in traditional medicine. Int. J. Pharm. Sci. Res. 2013, 4, 2770. [Google Scholar] [CrossRef]
- Cheok, C.Y.; Salman, H.A.K.; Sulaiman, R. Extraction and quantification of saponins: A review. Food Res. Int. 2014, 59, 16–40. [Google Scholar] [CrossRef]
- Bayman, P.; Lebrón, L.L.; Tremblay, R.; Lodge, D.J. Variation in endophytic fungi from roots and leaves of Lepanthes (Orchidaceae). New Phytol. 1997, 135, 143–149. [Google Scholar] [CrossRef] [PubMed]
- McGonigle, T.P.; Miller, M.H.; Evans, D.G.; Fairchild, G.L.; Swan, J.A. A new method which gives an objective measure of colonization of roots by vesicular—arbuscular mycorrhizal fungi. New Phytol. 1990, 115, 495–501. [Google Scholar] [CrossRef]
- Guo, L.-D.; Huang, G.-R.; Wang, Y. Seasonal and tissue age influences on endophytic fungi of Pinus tabulaeformis (Pinaceae) in the Dongling Mountains, Beijing. J. Integr. Plant Biol. 2008, 50, 997–1003. [Google Scholar] [CrossRef]
- Rogers, W.M.; Roberts, C.A.; Andrae, J.G.; Davis, D.K.; Rottinghaus, G.E.; Hill, N.S.; Kallenbach, R.L.; Spiers, D.E. Seasonal fluctuation of ergovaline and total ergot alkaloid concentrations in tall fescue regrowth. Crop Sci. 2011, 51, 1291–1296. [Google Scholar] [CrossRef]
- Susca, A.; Proctor, R.H.; Butchko, R.A.; Haidukowski, E.M.; Stea, G.; Logrieco, A.F.; Moretti, A. Variation in the fumonisin biosynthetic gene cluster in fumonisin-producing and nonproducing black aspergilli. Fungal Genet. Biol. 2014, 73, 39–52. [Google Scholar] [CrossRef]
- Anitha, D.; Vijaya, T.; Pragathi, D.; Reddy, N.V.; Mouli, K.C.; Venkateswarulu, N.; Bhargav, D.S. Isolation and characterization of endophytic fungi from endemic medicinal plants of Tirumala hills. Int. J. Life Sci. Biotechnol. Pharm. Res. 2013, 2, 367–373. [Google Scholar]
- Macia-Vicente, J.G.; Jansson, H.-B.; Abdullah, S.K.; Descals, E.; Salinas, J.; Lopez-Llorca, L.V. Fungal root endophytes from natural vegetation in Mediterranean environments with special reference to Fusarium spp. FEMS Microbiol. Ecol. 2008, 64, 90–105. [Google Scholar] [CrossRef]
- Noumeur, S.; Mancini, V.; Romanazzi, G. Activity of endophytic fungi from Artemisia absinthium on Botrytis cinerea. Acta Hortic. 2016, 1144, 101–104. [Google Scholar] [CrossRef]
- Mejia, L.; Rojas, E.I.; Maynard, Z.; Van Bael, S.; Arnold, A.E.; Hebbar, P.; Samuels, G.J.; Robbins, N.; Herre, E.A. Endophytic fungi as biocontrol agents of Theobroma cacao pathogens. Biol. Control 2008, 46, 4–14. [Google Scholar] [CrossRef]
- Rahul, Y.; Ajay, V.S.; Samiksha, J.; Manish, K. Antifungal and enzyme activity of endophytic fungi isolated from Ocimum sanctum and Aloe vera. Afr. J. Microbiol. Res. 2015, 9, 1783–1788. [Google Scholar] [CrossRef]
- Hongsanan, S.; Phookamsak, R.; Goonasekara, I.D.; Thambugala, K.M.; Hyde, K.D.; Bhat, J.D.; Suwannarach, N.; Cheewangkoon, R. Introducing a new pleosporalean family Sublophiostomataceae fam. nov. to accommodate Sublophiostoma gen. nov. Sci. Rep. 2021, 11, 1–10. [Google Scholar] [CrossRef]
- Zhang, Y.; Crous, P.W.; Schoch, C.L.; Hyde, K.D. Pleosporales. Fungal Divers. 2012, 53, 1–221. [Google Scholar] [CrossRef] [PubMed]
- Larone, D.H. Medically important fungi: A guide to identification-5th edition. Lab. Med. 2014, 45, e68–e69. [Google Scholar] [CrossRef]
- Chen, Q.; Hou, L.W.; Duan, W.J.; Crous, P.W.; Cai, L. Didymellaceae revisited. Stud. Mycol. 2017, 87, 105–159. [Google Scholar] [CrossRef]
- Taguiam, J.D.; Evallo, E.; Balendres, M.A. Epicoccum species: Ubiquitous plant pathogens and effective biological control agents. Eur. J. Plant Pathol. 2021, 159, 713–725. [Google Scholar] [CrossRef]
- Araújo, F.D.D.S.; Fávaro, L.C.D.L.; Araújo, W.L.; de Oliveira, F.L.; Aparicio, R.; Marsaioli, A.J. Epicolactone-Natural product isolated from the sugarcane endophytic fungus Epicoccum nigrum. Eur. J. Org. Chem. 2012, 27, 5225–5230. [Google Scholar] [CrossRef]
- Beasley, D.R.; Joyce, D.C.; Coates, L.M.; Wearing, A.H. Saprophytic microorganisms with potential for biological control of Botrytis cinerea on Geraldton waxflower flower. Aust. J. Exp. Agric. 2001, 41, 697–703. [Google Scholar] [CrossRef]
- Taguiam, J.D.; Evallo, E.; Bengoa, J.; Maghirang, R.; Balendres, M.A. Pathogenicity of Epicoccum sorghinum towards dragon fruits (Hylocereus species) and In Vitro evaluation of chemicals with antifungal activity. J. Phytopathol. 2020, 168, 303–310. [Google Scholar] [CrossRef]
- Aveskamp, M.M.; Verkley, G.J.M.; De Gruyter, J.; Murace, M.A.; Perelló, A.; Woudenberg, J.H.C.; Groenewald, J.Z.; Crous, P.W. DNA phylogeny reveals polyphyly of Phoma section Peyronellaea and multiple taxonomic novelties. Mycologia 2009, 101, 363–382. [Google Scholar] [CrossRef] [PubMed]
- Bennett, A.; Ponder, M.M.; Garcia-Diaz, J. Phoma infections: Classification, potential food sources, and their clinical impact. Microorganisms 2018, 6, 58. [Google Scholar] [CrossRef] [PubMed]
- De Gruyter, J.; Woudenberg, J.H.C.; Aveskamp, M.M.; Verkley, G.J.M.; Groenewald, J.Z.; Crous, P.W. Redisposition of phoma-like anamorphs in Pleosporales. Stud. Mycol. 2013, 75, 1–36. [Google Scholar] [CrossRef] [PubMed]
- Hou, L.; Groenewald, J.; Pfenning, L.; Yarden, O.; Crous, P.; Cai, L. The phoma-like dilemma. Stud. Mycol. 2020, 96, 309–396. [Google Scholar] [CrossRef]
- Wang, L.; Xu, B.-G.; Wang, J.-Y.; Su, Z.-Z.; Lin, F.-C.; Zhang, C.-L.; Kubicek, C.P. Bioactive metabolites from Phoma species, an endophytic fungus from the Chinese medicinal plant Arisaema erubescens. Appl. Microbiol. Biotechnol. 2012, 93, 1231–1239. [Google Scholar] [CrossRef] [PubMed]
- Alcock, A.; Elmer, P.; Marsden, R.; Parry, F. Inhibition of Botrytis cinerea by epirodin: A secondary metabolite from New Zealand isolates of Epicoccum nigrum. J. Phytopathol. 2015, 163, 841–852. [Google Scholar] [CrossRef]
- Gupta, S.; Kaul, S.; Singh, B.; Vishwakarma, R.A.; Dhar, M.K. Production of gentisyl alcohol from Phoma herbarum endophytic in Curcuma longa L. and its antagonistic activity towards leaf spot pathogen Colletotrichum gloeosporioides. Appl. Biochem. Biotechnol. 2016, 180, 1093–1109. [Google Scholar] [CrossRef]
- Song, X.; Li, Y.; Hu, Y.; Guo, W.; Wu, Z.; Zhang, Y.; Cao, Z. Investigation of endophytes from blueberry roots with antifungal activity and plant growth enhancement. Rhizosphere 2021, 20, 100454. [Google Scholar] [CrossRef]
- Kaliňák, M.; Barátová, V.; Gallová, E.; Ondrušová, Z.; Hudecová, D. Secondary metabolite production of Epicoccum sp. isolated from lignite. Acta Chim. Slovaca 2013, 6, 42–48. [Google Scholar] [CrossRef]
- Hussain, H.; Kock, I.; Al-Harrasi, A.; Al-Rawahi, A.; Abbas, G.; Green, I.R.; Shah, A.; Badshah, A.; Saleem, M.; Draeger, S.; et al. Antimicrobial chemical constituents from endophytic fungus Phoma sp. Asian Pac. J. Trop. Med. 2014, 7, 699–702. [Google Scholar] [CrossRef]
- Fatima, N.; Ismail, T.; Muhammad, S.A.; Jadoon, M.; Ahmed, S.; Azhar, S.; Mumtaz, A. Epicoccum sp., an emerging source of unique bioactive metabolites. Acta Pol. Pharm. Drug Res. 2016, 73, 13–21. [Google Scholar]
- Deffieux, G.; Filleau, M.-J.; Baute, R. New antibiotics from the fungus Epicoccum nigrum. III. Epicorazine B: Structure elucidation and absolute configuration. J. Antibiot. 1978, 31, 1106–1109. [Google Scholar] [CrossRef] [PubMed]
- Braga, R.M.; Padilla, G.; Araújo, W.L. The biotechnological potential of Epicoccum spp.: Diversity of secondary metabolites. Crit. Rev. Microbiol. 2018, 44, 759–778. [Google Scholar] [CrossRef] [PubMed]
- Shentu, X.; Zhan, X.; Ma, Z.; Yu, X.; Zhang, C.-X. Antifungal activity of metabolites of the endophytic fungus Trichoderma brevicompactum from garlic. Braz. J. Microbiol. 2014, 45, 248–254. [Google Scholar] [CrossRef] [PubMed]
- Paulsamy, S.; Karthika, K. TLC and HPTLC fingerprints of various secondary metabolites in the stem of the traditional medicinal climber, Solena amplexiacaulis. Indian J. Pharm. Sci. 2015, 77, 111–116. [Google Scholar] [CrossRef] [PubMed]
- Le, A.V.; Parks, S.E.; Nguyen, M.H.; Roach, P.D. Improving the vanillin-sulphuric acid method for quantifying total saponins. Technologies 2018, 6, 84. [Google Scholar] [CrossRef]
- Gong, A.; Zhou, T.; Xiao, C.; Jiang, W.; Zhou, Y.; Zhang, J.; Liang, Q.; Yang, C.; Zheng, W.; Zhang, C. Association between dipsacus saponin VI level and diversity of endophytic fungi in roots of Dipsacus asperoides. World J. Microbiol. Biotechnol. 2019, 35, 1–14. [Google Scholar] [CrossRef]
- Oikawa, H.; Toshima, H.; Ohashi, S.; König, W.A.; Kenmoku, H.; Sassa, T. Diversity of diterpene hydrocarbons in fungus Phoma betae. Tetrahedron Lett. 2001, 42, 2329–2332. [Google Scholar] [CrossRef]

| Plant. | Fungal Isolate |
|---|---|
| E. chiloensis | Ech1 |
| Ech2 | |
| Ech3 | |
| Ech4 | |
| Ech5 | |
| Ech6 | |
| B. linearis | Bl1 |
| Bl2 | |
| Bl3 | |
| Bl4 |
Publisher’s Note: MDPI stays neutral with regard to jurisdictional claims in published maps and institutional affiliations. |
© 2022 by the authors. Licensee MDPI, Basel, Switzerland. This article is an open access article distributed under the terms and conditions of the Creative Commons Attribution (CC BY) license (https://creativecommons.org/licenses/by/4.0/).
Share and Cite
Castro, P.; Parada, R.; Corrial, C.; Mendoza, L.; Cotoras, M. Endophytic Fungi Isolated from Baccharis linearis and Echinopsis chiloensis with Antifungal Activity against Botrytis cinerea. J. Fungi 2022, 8, 197. https://doi.org/10.3390/jof8020197
Castro P, Parada R, Corrial C, Mendoza L, Cotoras M. Endophytic Fungi Isolated from Baccharis linearis and Echinopsis chiloensis with Antifungal Activity against Botrytis cinerea. Journal of Fungi. 2022; 8(2):197. https://doi.org/10.3390/jof8020197
Chicago/Turabian StyleCastro, Paulo, Rodolfo Parada, Carlos Corrial, Leonora Mendoza, and Milena Cotoras. 2022. "Endophytic Fungi Isolated from Baccharis linearis and Echinopsis chiloensis with Antifungal Activity against Botrytis cinerea" Journal of Fungi 8, no. 2: 197. https://doi.org/10.3390/jof8020197
APA StyleCastro, P., Parada, R., Corrial, C., Mendoza, L., & Cotoras, M. (2022). Endophytic Fungi Isolated from Baccharis linearis and Echinopsis chiloensis with Antifungal Activity against Botrytis cinerea. Journal of Fungi, 8(2), 197. https://doi.org/10.3390/jof8020197

